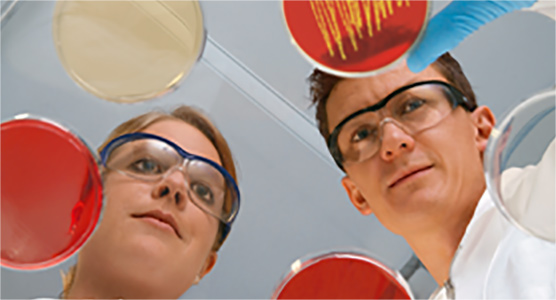
image

Nutzungsbedingungen
Zuletzt aktualisiert Mai 2019
Diese Website wird von Boehringer Ingelheim RCV GmbH & Co KG mit Hauptgeschäftssitz in Wien (nachstehend „Boehringer Ingelheim“, „wir“, „uns“) oder einem Mitglied des Unternehmensverbandes Boehringer Ingelheim bereitgestellt.
Sie müssen die folgenden Regeln einhalten, wenn Sie die Website nutzen:
1. Berechtigung, Pharmakovigilanz
1.1. Entsprechend geltendem Gesetz dürfen Informationen zu verschreibungspflichtigen Pharmazeutika nur Gesundheitsfachkräften offengelegt werden. Sie müssen sich daher registrieren, bevor Sie Zugriff auf bestimmte Websites erhalten.
1.2. Der Inhalt unserer Website bezieht sich ausschließlich auf die Marktzulassung der entsprechenden Pharmazeutika in Österreich. Die Marktzulassungen für gleiche/ähnliche Pharmazeutika können in anderen Ländern variieren. Wenn Sie von außerhalb Österreichs auf unsere Website zugreifen, beachten Sie bitte IMMER die in Ihrem Land gültige Marktzulassung und Produktinformation. Die Website ist nur zur Nutzung durch Gesundheitsfachkräfte gemäß §§ 50 ff Arzneimittelgesetz (AMG) gedacht.
1.3. Bitte beachten Sie, dass Sie unter Umständen gesetzlich verpflichtet sind, die aktuellen technischen Informationen für Gesundheitsfachkräfte zu beachten.
1.4. Diese Website ist nicht zur Meldung von unerwünschten Ereignissen Pharmakovigilanz relevanten Informationen (z.B. Off-label-use, Überdosierung, Medikamenten-Abusus, Medikationsfehler, Wirkungslosigkeit, Arzneimittelexposition während der Schwangerschaft…) oder Beschwerden zu einem Produkt von Boehringer Ingelheim gedacht. Bitte melden Sie unerwünschte Ereignisse/Pharmakovigilanz relevante Informationen oder Produktbeschwerden an die Pharmakovigilanz Österreich:
Pharmakovigilanz Medizin Österreich
Tel.: +43(1)801 05-2099
Fax: +43(1)801 05-6384
e-mail: PV_local_Austria@boehringer-ingelheim.com
Welche PV Ereignisse oder Situationen sollten eine Meldung auslösen?
-
Unerwünschte Ereignisse, Nebenwirkungen, anormale Laborbefunde
-
UE, die nach dem Absetzen des Medikaments oder nach Medikamenten Interaktionen auftreten
-
Medikamenten -Abusus, -Missbrauch, mit und ohne Ereignis
-
Überdosierung, vorsätzlich oder unbeabsichtigt, mit und ohne Ereignis
-
Fehler bei der medikamentösen Behandlung (Medikationsfehler), mit und ohne Ereignis
-
Off-label Anwendung, mit und ohne Ereignis
-
Wirkungslosigkeit
-
Berufsbedingte Exposition
-
Arzneimittelexposition während der Schwangerschaft (über Mutter oder Vater), mit und ohne UE
-
Unerwünschte Ereignisse bei Säuglingen, die gestillt werden
-
Übertragung von Krankheitserregern
-
Unerwarteter Nutzen
2. Nutzung der Inhalte
2.1. Alle auf dieser und über diese Website oder von uns auf einem anderen Weg bereitgestellten Informationen sind Eigentum des Unternehmensverbandes Boehringer Ingelheim und sind urheberrechtlich geschützt. Es wird eine Erlaubnis zur Nutzung von Dokumenten (wie White Papers, Pressemitteilungen, Datenblätter und FAQs) erteilt, vorausgesetzt, dass (1) dieser Vermerk in allen Kopien erscheint und dass insbesondere sowohl der Urheberrechtsvermerk als auch dieser Erlaubnisvermerk erscheinen, (2) die Nutzung derartiger Dokumente nur zum informativen, medialen, nicht kommerziellen Zweck oder zum persönlichen Gebrauch erfolgt und die Dokumente nicht kopiert oder auf einem Netzwerkcomputer veröffentlicht oder in kommerziellen Medien verbreitet werden, und (3) die Dokumente nicht verändert werden. Die Nutzung zu einem anderen Zweck ist ausdrücklich untersagt und kann schwere zivil- und strafrechtliche Folgen nach sich ziehen. Verstöße werden strafrechtlich verfolgt.
2.2. Die oben genannte Erlaubnis umfasst nicht die Nutzung des Designs oder Layouts von Websites oder Materialien, die einem der Unternehmen des Boehringer-Ingelheim-Unternehmensverbandes gehören, von diesem betrieben, lizenziert oder kontrolliert werden. Elemente der Websites und Materialien sind durch Urheberrechte, Gesetzte zu Handelsaufmachung, Marken, unfairem Wettbewerb und andere Gesetze geschützt und dürfen weder ganz noch teilweise kopiert oder nachgeahmt werden. Keine Marken, Handelsaufmachungen, Logos, Grafiken, Tonaufnahmen oder Bilder von einer Website oder Materialien dürfen kopiert oder neu übertragen werden, außer das spezifische Boehringer-Ingelheim-Unternehmen, das Inhaber diese Rechte ist, hat dies ausdrücklich erlaubt.
2.3. Alle nicht ausdrücklich hier gewährten Rechte sind vorbehalten.
3. Markenhinweis
Die Markennamen von in diesem Dokument oder anderen Materialien genannten Boehringer-Ingelheim-Produkten, unabhängig davon, ob sie fett gedruckt oder mit dem Markensymbol ® erscheinen, sind Marken von Unternehmen des Unternehmensverbandes Boehringer Ingelheim, einschließlich von uns. Die in diesem Dokument genannten Namen tatsächlicher Unternehmen und Produkte können die Marken der entsprechenden Eigentümer sein. Die Nutzung dieser Marken, des Unternehmensnamen Boehringer Ingelheim und des Unternehmenslogos, außer in dem hier angegebenen Umfang, ist ausdrücklich untersagt und stellt unter Umständen einen Verstoß gegen das Strafrecht dar. Die hier angesprochenen Produkte können in anderen Ländern andere Markennamen, Kennzeichnungen, Produktaufmachungen und Stärken haben. Bitte wenden Sie sich an das verbundene Unternehmen vor Ort, falls Sie weitere Klärung benötigen.
4. Verantwortung und Haftpflicht
4.1. Der Unternehmensverband Boehringer Ingelheim und/oder seine jeweiligen Lieferanten machen keine Zusicherungen über die Eignung der in den Dokumenten und zugehörigen, auf dieser Website veröffentlichten Grafiken enthaltenen Informationen. Alle diese Dokumente und zugehörigen Grafiken werden in der vorliegenden Form, ohne jegliche Garantie, bereitgestellt. Der Unternehmensverband Boehringer Ingelheim und/oder seine jeweiligen Lieferanten lehnen hiermit alle Garantien und Bedingungen in Bezug auf diese Informationen ab, einschließlich alle implizierten Garantien und Bedingungen der Marktgängigkeit, Eignung für einen bestimmten Zweck, Rechtsanspruch und Nichtverletzung von Rechten Dritter. Der Zugriff auf die und die Nutzung der Inhalte erfolgt auf eigenes Risiko der Benutzer. In keinem Fall haften Unternehmen des Unternehmensverbandes Boehringer Ingelheim und/oder seine jeweiligen Lieferanten für konkrete, indirekte oder Folgeschäden oder jegliche andere Schäden aufgrund von Nutzungsausfall, Daten- oder Gewinnverlust, gleich ob durch eine Vertragshandlung, Fahrlässigkeit oder andere unerlaubte Handlungen aufgrund von oder im Zusammenhang mit der Verwendung oder Ausführung der auf dieser Website zur Verfügung stehenden Informationen entstanden.
4.2. Sie sind für die Verwaltung Ihrer eigenen Anmeldedaten, wie Login-ID und Passwort, verantwortlich. Sie werden Ihre Login-ID oder Ihr Passwort niemandem gegenüber offenlegen, leihen, übertragen oder verkaufen. Sie sind für alle Aktivitäten, die unter Nutzung Ihrer Login-ID und Ihres Passwort erfolgen, vollständig verantwortlich. Sie stimmen zu, uns unverzüglich über jegliche unbefugte Nutzung Ihrer ID und Ihres Passworts zu informieren und unsere Anweisungen zu befolgen. Der Unternehmensverband Boehringer Ingelheim und/oder seine jeweiligen Lieferanten haften nicht für Verluste oder Schäden, die aus Ihrer Nichtbefolgung dieser Pflichten entstehen.
4.3. Dokumente zu pharmazeutischen Produkten sind nicht als Alternative zu einer Beratung von einer Gesundheitsfachkraft oder einer anderen qualifizierten Person zu nutzen.
4.4. Die auf dieser Website veröffentlichten Dokumente und zugehörigen Grafiken können technische Ungenauigkeiten oder Druckfehler enthalten. Diese Informationen werden gelegentlich verändert. Der Unternehmensverband Boehringer Ingelheim und/oder seine jeweiligen Lieferanten können jederzeit Verbesserungen und/oder Änderungen an dem/den hier beschriebenen Produkt(en) und/oder Programm(en) vornehmen.
4.5. In keinem Fall haftet der Unternehmensverbandes Boehringer Ingelheim und/oder seine jeweiligen Lieferanten für konkrete, indirekte oder Folgeschäden oder jegliche andere Schäden aufgrund von Nutzungsausfall, Daten- oder Gewinnverlust, gleich ob durch eine Vertragshandlung, Fahrlässigkeit oder andere unerlaubte Handlungen aufgrund von oder im Zusammenhang mit der Verwendung oder Ausführung von Software, Dokumenten, der Bereitstellung oder Nichtbereitstellung von Dienstleistungen oder der auf dieser Website zur Verfügung stehenden Informationen entstanden.
5. Links zu Drittwebsites
Einige Links leiten Sie zu externen Websites weiter. Falls nicht anderweitig im Impressum der externen Website angegeben, unterliegen die verknüpften Websites nicht der Kontrolle des Unternehmensverbandes Boehringer Ingelheim und kein Unternehmen des Unternehmensverbandes Boehringer Ingelheim ist für die Inhalte dieser verknüpften Websites oder auf den verknüpften Websites angegebene Links oder für Änderungen oder Aktualisierungen derartiger Websites verantwortlich. Ebenso wenig ist ein Unternehmen des Unternehmensverbandes Boehringer Ingelheim verantwortlich für Webcasting oder eine andere Form von Übertragung, die von einer verknüpften Website empfangen wird. Diese Links werden Ihnen nur als eine Annehmlichkeit zur Verfügung gestellt und die Integration eines Links impliziert keine Empfehlung der Website durch den Unternehmensverband Boehringer Ingelheim.
6. Verschiedenes
6.1. Wir behalten uns das Recht vor, diese Nutzungsbedingungen zu ändern, wenn wir Sie per E-Mail (oder durch Veröffentlichung eines auffälligen Hinweises auf der Website) darüber informieren und Sie die Möglichkeit haben, innerhalb von zwei Wochen zu widersprechen. Wenn Sie nicht widersprechen, werden die geänderten Nutzungsbedingungen gültig.
6.2. Diese Nutzungsbedingungen unterliegen österreichischem Recht. Falls eine Bestimmung dieser Nutzungsbedingungen ungültig ist, bleiben die restlichen Bestimmungen dieser Nutzungsbedingungen in Kraft.